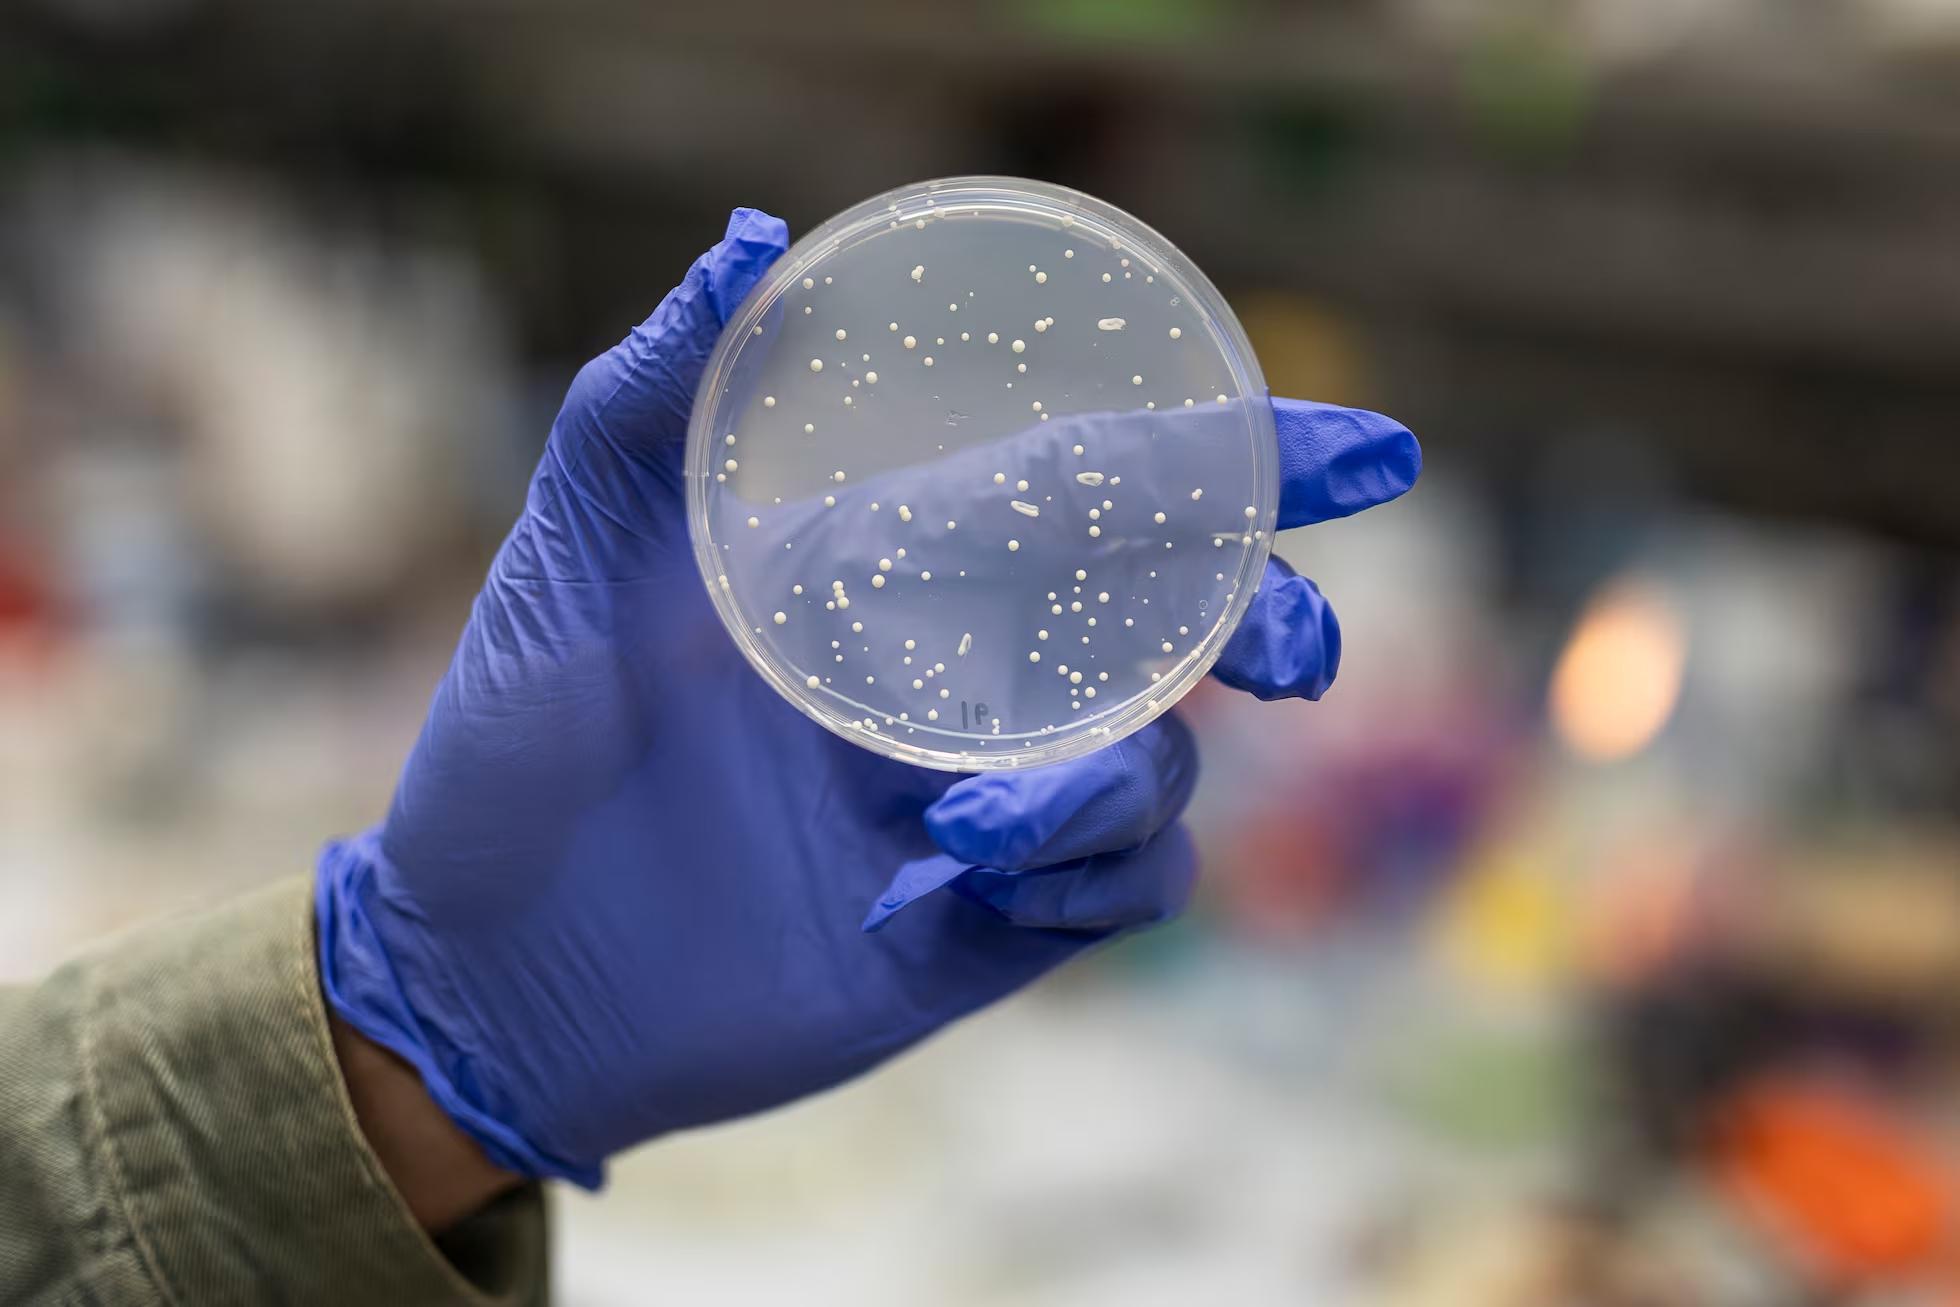

《自然》重大突破:首個"人類結構域組"問世,破解基因突變真相!

在當前的醫療實踐中,許多遺傳性疾病的治療往往面臨着一個關鍵挑戰:雖然我們知道疾病與基因突變有關,但卻無法準確理解每個突變具體如何影響人體功能。這導致很多治療方案只能針對症狀,而非病因本身。
突破性發現
2025年1月8日,《自然》雜誌發表了一項具有里程碑意義的研究。巴塞羅那基因組調控中心的研究團隊成功創建了首個"人類結構域組",系統性地分析了563,000個DNA突變如何影響蛋白質功能。這是迄今爲止規模最大的基因突變系統性研究。

基礎知識解讀
爲了理解這項突破的意義,我們需要先了解幾個基本概念:
DNA和蛋白質的關係:DNA就像一本包含20,000個配方的烹飪手冊,每個配方(基因)都告訴細胞如何製造特定的蛋白質,蛋白質是執行人體各項功能的關鍵分子。
基因突變的影響:突變就像配方中的錯別字,有些錯別字會導致"菜品"(蛋白質)完全變味,有些則可能影響不大。

研究突破詳解
研究團隊採用了一個創新的實驗系統:
實驗設計:改造酵母細胞作爲"檢測器",將人類蛋白質導入酵母細胞,通過觀察酵母生長情況評估蛋白質功能。
關鍵發現:60%的致病突變會影響蛋白質穩定性,不同類型的疾病可能有不同的致病機制。以白內障爲例,72%的相關突變導致晶狀體蛋白結構紊亂,就像清晰的玻璃變成了毛玻璃。

研究團隊的努力歷程
這項研究的主要負責人是32歲的安東尼·貝爾特蘭(Antoni Beltran),和他的導師本萊納(Ben Lehner,英國皇家學會成員)。他們從2021年開始構思這個項目,經過近四年的努力,終於建立起了這個龐大的數據庫。
臨牀應用前景
這項研究爲未來的疾病治療開闢了新的可能:
短期影響:可以幫助醫生更準確理解患者的具體病因,爲藥物研發提供更明確的方向。
中期展望:可以開發針對特定突變類型的靶向藥物,實現更精準的個性化治療。
長期目標:建立完整的人類蛋白質突變圖譜,開發預測突變影響的人工智能工具。
研究侷限性
需要客觀指出,這項研究仍有一些重要限制:
覆蓋範圍:目前僅分析了人類蛋白質的2.5%,只研究了蛋白質的關鍵區域,而非完整蛋白質。
實驗系統:使用酵母細胞可能無法完全模擬人體環境,某些複雜的蛋白質互作可能未被觀察到。
雖然這項突破性研究目前只覆蓋了人類蛋白質的2.5%,但它已經爲我們打開了理解遺傳疾病的新窗口。正如科學家們所言,這就像是我們終於拿到了一本詳細的維修手冊,雖然還沒看完,但已經能幫我們解決很多問題了。
參考文獻:
Beltran, A., Jiang, X., Shen, Y. et al. Site-saturation mutagenesis of 500 human protein domains. Nature (2025). https://doi.org/10.1038/s41586-024-08370-4

















